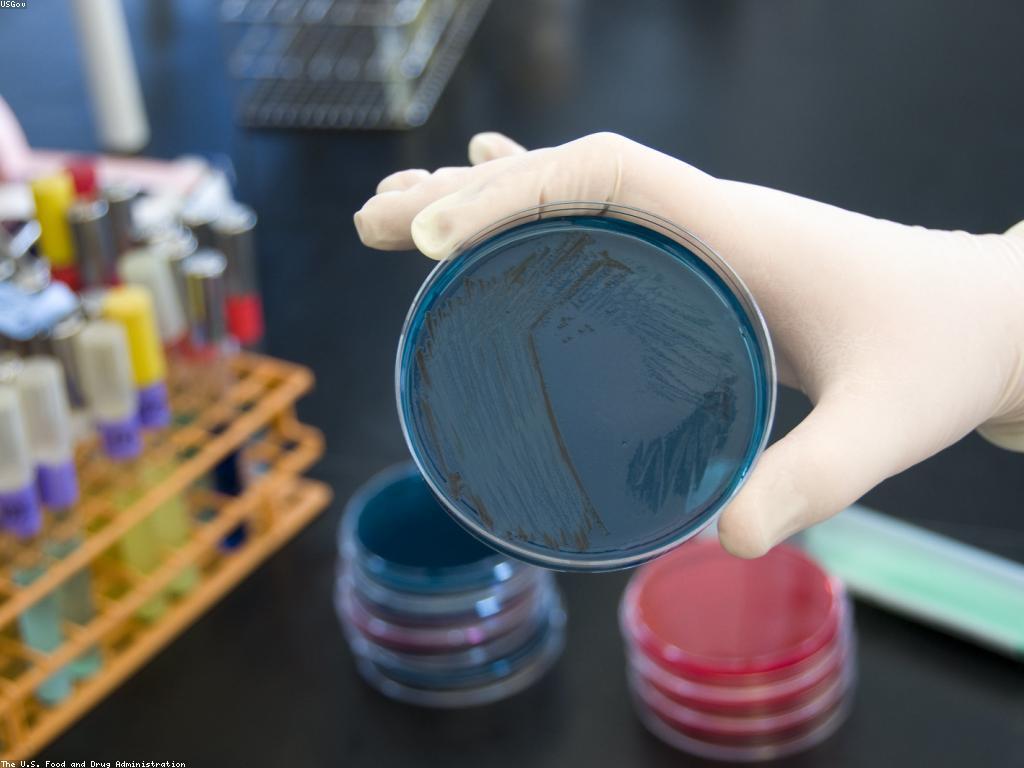
វិធីសាស្ត្រប្រសើរដើម្បីធ្វើតេស្តនិងការប្រជុំន

វិធីសាស្ត្រប្រសើរដើម្បីធ្វើតេស្តនិងការប្រជុំន
វិធីសាស្ត្រប្រសើរដើម្បីធ្វើតេស្តនិងការប្រជុំន
ការធ្វើតេស្តនិងការប្រជុំនជាជំហានសំខាន់ក្នុងការបញ្ចេញយោបល់និងទទួលបានព័ត៌មានពីអ្នកប្រើប្រាស់។ វាជាផ្នែកមួយដែលអាចជួយឲ្យអ្នករៀបចំការពិនិត្យនិងការស្ទង់មតិដើម្បីធានាថាផលិតផលឬសេវាកម្មរបស់អ្នកមានគុណភាពប្រកបដោយប្រសិទ្ធភាព។
ក្នុងអត្ថបទនេះយើងនឹងពិភាក្សាអំពីវិធីសាស្ត្រប្រសើរដែលអាចប្រើប្រាស់បាននៅក្នុងការធ្វើតេស្តនិងការប្រជុំន។ វិធីសាស្ត្រទាំងនេះនឹងជួយឲ្យអ្នកទទួលបានទិន្នន័យដែលត្រឹមត្រូវនិងអាចប្រើប្រាស់បាន។
1. ការបង្កើតសំណួរដែលមានប្រសិទ្ធភាព
ការបង្កើតសំណួរដែលមានប្រសិទ្ធភាពគឺជាផ្នែកសំខាន់បំផុតមួយក្នុងការធ្វើតេស្ត។ សំណួរដែលមានភាពជាក់លាក់និងច្បាស់នឹងជួយឲ្យអ្នកទទួលបានព័ត៌មានដែលត្រឹមត្រូវ។

ការបង្កើតសំណួរមានគុណភាពនឹងអាចជួយអ្នកកំណត់កម្រិតនៃការទទួលបានមតិពីអ្នកប្រើប្រាស់។ ប្រសិនបើសំណួរនោះមានភាពជាស្រាល ឬមិនច្បាស់ អ្នកប្រើប្រាស់អាចមិនអាចផ្តល់ព័ត៌មានដែលត្រឹមត្រូវបានទេ។
2. ការប្រើប្រាស់បច្ចេកវិទ្យាដើម្បីប្រមូលទិន្នន័យ
បច្ចេកវិទ្យាដំណើរការនៅសម័យនេះអាចជួយអ្នកក្នុងការប្រមូលទិន្នន័យយ៉ាងមានប្រសិទ្ធភាព។ ការប្រើប្រាស់កម្មវិធីសំរាប់ការប្រជុំនអាចជួយឲ្យអ្នកទទួលបានទិន្នន័យដែលមានអត្ថន័យ។
3. ការវិភាក្សានិងកែលម្អ
ក្រោយការធ្វើតេស្តនិងការប្រជុំន អ្នកគួរតែធ្វើការវិភាក្សានិងវាយតម្លៃលទ្ធផលដែលបានទទួល។ ការកែលម្អគឺជាផ្នែកមួយដែលសំខាន់ក្នុងកាធ្វើកំណែទម្រង់និងការលើកកម្ពស់ផលិតផលឬសេវាកម្ម។

ការធ្វើការវិភាក្សានឹងអាចជួយអ្នកកំណត់ចំណុចខ្សោយនិងអត្ថប្រយោជន៍នៅក្នុងសេវាកម្មរបស់អ្នក ហើយនឹងជួយឲ្យអ្នកកែលម្អប្រសិទ្ធភាព។
សន្និដ្ឋាន
ការធ្វើតេស្តនិងការប្រជុំនគឺជាផ្នែកសំខាន់ក្នុងការធ្វើឲ្យផលិតផលឬសេវាកម្មរបស់អ្នកមានគុណភាពល្អ។ ប្រសិនបើអ្នកអនុវត្តវិធីសាស្ត្រប្រសើរដែលបានរៀបរាប់ខាងលើ នោះអ្នកនឹងអាចទទួលបានលទ្ធផលដែលកាន់តែប្រសើរ។
មតិអ្នកប្រើ
David ម្សិលមិញ
ខ្លឹមសារច្បាស់លាស់ ងាយយល់ណាស់។
WebExplorer ១០ នាទីមុន
អត្ថបទល្អណាស់! អរគុណសម្រាប់ការចែករំលែក។
Kevin មុននេះបន្តិច
សូមអរគុណសម្រាប់ព័ត៌មានដ៏ល្អនេះ។
Daniel ២ ម៉ោងមុន
ពិតជាអ្វីដែលខ្ញុំកំពុងស្វែងរក។
Chris ២ ម៉ោងមុន
អរគុណច្រើនដែលបានផ្តល់ចំណេះដឹងថ្មីៗ។
បញ្ចេញមតិ